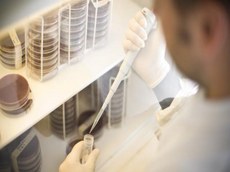

Notícias
Fapesq e British Council lançam chamada para Researcher Links Workshops 2017- 2018
A Fundação de Apoio à Pesquisa do Estado da Paraíba (Fapesq) e o British Council estão com Chamada Pública aberta para a realização de atividades, dentro do escopo de trabalho do Fundo Newton: a Chamada Pública Researcher Links Workshops Confap – edital 2017-18 (Workshops de Pesquisadores). O envio de propostas será aceito até o dia 13 de junho de 2017.
Researcher Links Workshops Confap – edital 2017-18
O programa Researcher Links tem como objetivo apoiar a realização de workshops científicos que sirvam como plataformas para a colaboração entre cientistas brasileiros e britânicos. Estes workshops são coordenados por pesquisadores seniores de reconhecida competência nos seus campos de atividades. Os dois coordenadores (um pesquisador britânico e um brasileiro) poderão identificar quatro outros pesquisadores líderes, dois de cada país, para participar como mentores, e os demais participantes deverão ser pesquisadores em início de carreira de ambos os países (entre 12 a 17 de cada país). Os workshops deverão ser em inglês e com duração de três a cinco dias.
A proposta deve trazer um benefício social para o Brasil, ou seja, demonstrar impacto direto ou indireto em populações vulneráveis ou de baixa renda. Todos os projetos financiados pelo Fundo Newton seguem os critérios da OECD para investimento tipo ODA (sigla em inglês para Assistência Internacional para o Desenvolvimento).
O valor disponível para o financiamento de cada workshop é de até 43 mil libras esterlinas. O edital (em inglês) e o formulário de inscrição para esta chamada estão disponíveis no site global do British Council (em inglês). A chamada permanecerá aberta até às dez horas da manhã, do horário de Brasília, do dia 13 de junho de 2017. Os workshops selecionados deverão ser realizados até 31 de agosto de 2018.
Estados – Participam desta Chamada, por meio de suas Fundações, os Estado de Alagoas (Fapeal), Distrito Federal (FAPDF), Espírito Santo (Fapes), Goiás (Fapeg), Maranhão (Fapema), Mato Grosso do Sul (Fundect), Minas Gerais (Fapemig), Pará (Fapespa), Paraíba (Fapesq), Paraná (Fundação Araucária), Pernambuco (Facepe), Santa Catarina (Fapesc) e São Paulo (Fapesp).
Temas – Os workshops devem abordar um dos seguintes temas:
• Agricultura – especialmente voltada à pequena propriedade;
• Clima e meio ambiente (mudança climática, tecnologia verde, desenvolvimento sustentável, serviços de ecossistema, escassez de recursos);
• Energia renovável e energia limpa;
• Educação;
• Crescimento econômico inclusivo;
• Saúde (doenças negligenciadas);
• Água e saneamento;
• Alimentação e nutrição (incluindo segurança alimentar);
• Mudança demográfica/migração/urbanização (foco em urbanização e direitos humanos e transformação urbana);
• Infraestrutura (infraestrutura para desenvolvimento – foco em comunidades remotas);
• Desastres humanitários e emergências;
• Governança, sociedade e conflito (transparência, accountability, instituições eficientes, direito à terra e recursos naturais com foco em populações indígenas, justiça criminal, diminuição da pobreza, desenvolvimento social, desigualdades estruturais, processos de pacificação [peace building] e sociedade civil);
• Coleta, análise de qualidade e acesso a dados relevantes aos índices de desenvolvimento (incluindo informações administrativas e estatísticas macroeconômicas);
• Zika vírus.
Parceiro britânico – A University UK (UUKi), instituição parceira, auxilia as organizações brasileiras a encontrar instituições com interesses similares no Reino Unido para projetos do British Council financiados pelo Fundo Newton. Para saber mais, escreva para newton@international.ac.uk, indicando o assunto “Researcher Links 2017/2018 – Brazil call”.
Ascom Fapesq com informações do CONFAP e British Council